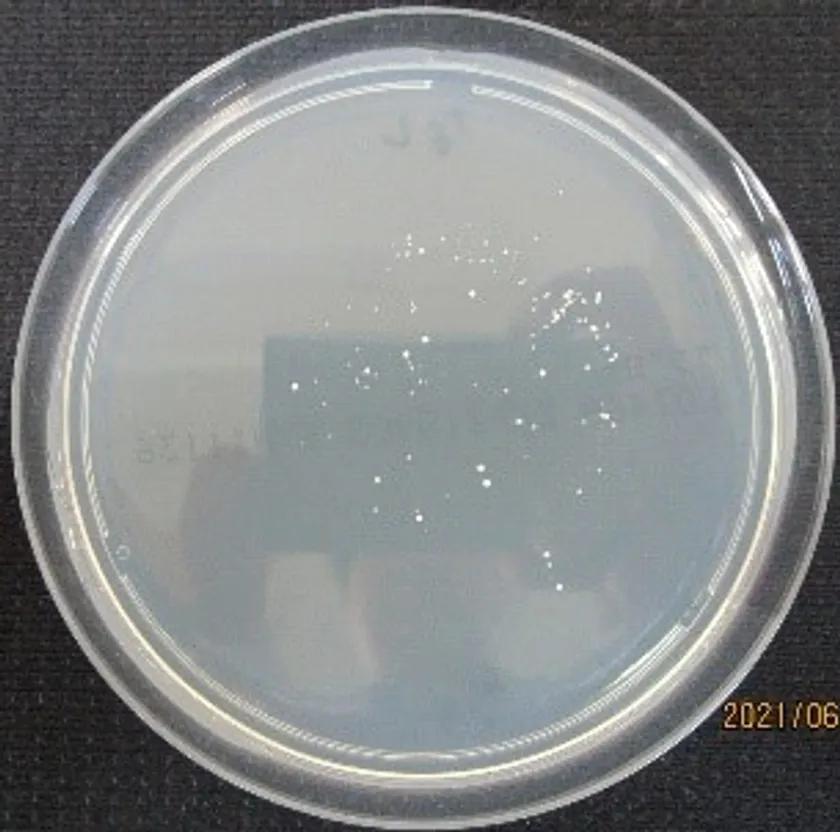

『UV殺菌ダスター』の出荷を開始 飲食店、レストラン、アクリル板の清掃には ハンディー殺菌ランプで手間いらず!気になるものは1秒で殺菌!
世界で初めて胃カメラ用の電球を製作した細渕電球株式会社(本社:東京都荒川区、代表取締役:高橋 建志)は、光による殺菌でウイルスの感染防止ができる『UV殺菌ダスター』を開発、2021年7月よりサンプル製品を出荷することをお知らせいたします。
『UV殺菌ダスター』は、オーダーメイド可能です。乾電池駆動でのコードレス化、対象物が反射傘でカバーされた時だけ照射させる安全性を重視した設計となっております。
■特徴
(1)運用
アクリル板、テーブル、椅子、自販機等の操作パネル、ATM、リモコン、スマホ等(平面的なもの、薄めの小物類推奨)
(2)冷陰極管
病原体破壊作用が最も高い254nm(UV-C)の波長を中心に照射。
(3)光による殺菌
(4)オゾンによる消臭も可能
同時にオゾンを発生し、消臭効果を発揮。
(5)高品質
信頼と安心の日本品質(電球職人による手作り)。
■商製品の特長・仕様
電源 :アルカリ単三電池 8本(12V)
大きさ :265W×101H×122D(mm)
重量 :455g(電池含まず)
サンプル出荷:2021年7月より(価格未定)

UV殺菌ダスター 照射スイッチ

UV殺菌ダスター グリップ

UV グラフ
照射前

1秒照射 距離1cm・8W
■開発・製造
細渕電球株式会社
〒116-0013 東京都荒川区西日暮里1-27-12
TEL : 03-3805-2181
FAX : 03-3805-2296
MAIL: info@hosobuchi-lamp.co.jp

















